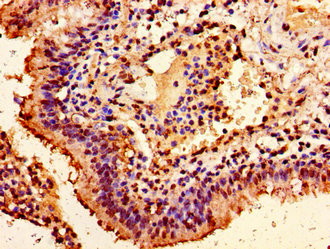

HIST1H1E (Ab-63) Antibody
-
中文名稱:HIST1H1E (Ab-63)兔多克隆抗體
-
貨號:CSB-PA010380PA63ncrHU
-
規(guī)格:¥660
-
圖片:
-
其他:
產(chǎn)品詳情
-
產(chǎn)品名稱:Rabbit anti-Homo sapiens (Human) HIST1H1E Polyclonal antibody
-
Uniprot No.:
-
基因名:HIST1H1E
-
別名:H1 histone family member 4 antibody; H1.4 antibody; H14_HUMAN antibody; H1E antibody; H1F4 antibody; Hist1h1e antibody; Histone 1 H1e antibody; Histone cluster 1 H1e antibody; Histone H1 antibody; Histone H1.4 antibody; Histone H1B antibody; MGC116819 antibody
-
宿主:Rabbit
-
反應(yīng)種屬:Human
-
免疫原:Peptide sequence around site of Lys (63) derived from Human Histone H1.4
-
免疫原種屬:Homo sapiens (Human)
-
標(biāo)記方式:Non-conjugated
-
克隆類型:Polyclonal
-
抗體亞型:IgG
-
純化方式:Antigen Affinity Purified
-
濃度:It differs from different batches. Please contact us to confirm it.
-
保存緩沖液:Preservative: 0.03% Proclin 300
Constituents: 50% Glycerol, 0.01M PBS, pH 7.4 -
產(chǎn)品提供形式:Liquid
-
應(yīng)用范圍:ELISA, IHC
-
推薦稀釋比:
Application Recommended Dilution IHC 1:20-1:200 -
Protocols:
-
儲存條件:Upon receipt, store at -20°C or -80°C. Avoid repeated freeze.
-
貨期:Basically, we can dispatch the products out in 1-3 working days after receiving your orders. Delivery time maybe differs from different purchasing way or location, please kindly consult your local distributors for specific delivery time.
-
用途:For Research Use Only. Not for use in diagnostic or therapeutic procedures.
相關(guān)產(chǎn)品
靶點詳情
-
功能:Histone H1 protein binds to linker DNA between nucleosomes forming the macromolecular structure known as the chromatin fiber. Histones H1 are necessary for the condensation of nucleosome chains into higher-order structured fibers. Acts also as a regulator of individual gene transcription through chromatin remodeling, nucleosome spacing and DNA methylation.
-
基因功能參考文獻(xiàn):
- Results show that histones H1.2 and H1.4 were observed in MDA-MB-231 metastatic breast cancer cells. The phosphorylation at S173 of histone H1.2 and S172, S187, T18, T146, and T154 of H1.4 significantly increases during M phase suggesting that these events are cell cycle-dependent. PMID: 26209608
- This study identified and confirmed HIST1H1E protein changes within the postsynaptic density in schizophrenia. PMID: 25048004
- the N-terminal domain of H1 is an important determinant of affinity and specificity of H1-chromatin interactions. PMID: 22425985
- PKA-mediated H1.4S35 phosphorylation dissociates H1.4 from mitotic chromatin but also suggest that this phosphorylation is necessary for specific mitotic functions. PMID: 21852232
- Allele-specific underacetylation of histone H4 downstream from promoter is associated with X-inactivation in human cells. PMID: 12498347
- the lysine residue adjacent to the phosphorylation site found on the serine residue on the H1.4 peptide KARKSAGAAKR was also shown to be methylated, raising the question of whether the hypothesized "methyl/phos" switch could be extended to linker histones PMID: 15595731
- Dynamic Histone H1 Isotype 4 Methylation and Demethylation by Histone Lysine Methyltransferase G9a/KMT1C and the Jumonji Domain-containing JMJD2/KDM4 Proteins PMID: 19144645
顯示更多
收起更多
-
相關(guān)疾病:Rahman syndrome (RMNS)
-
亞細(xì)胞定位:Nucleus. Chromosome. Note=Mainly localizes in heterochromatin. Dysplays a punctuate staining pattern in the nucleus.
-
蛋白家族:Histone H1/H5 family
-
數(shù)據(jù)庫鏈接:
Most popular with customers
-
-
YWHAB Recombinant Monoclonal Antibody
Applications: ELISA, WB, IHC, IF, FC
Species Reactivity: Human, Mouse, Rat
-
Phospho-YAP1 (S127) Recombinant Monoclonal Antibody
Applications: ELISA, WB, IHC
Species Reactivity: Human
-
-
-
-
-